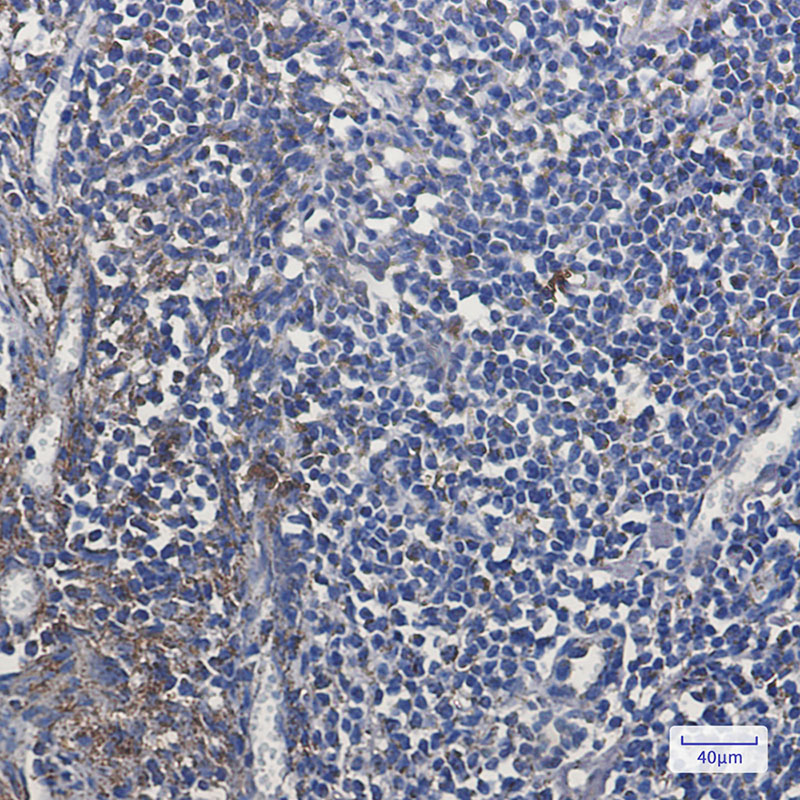

-
分类: 科研抗体货号: P21689别名: MT-CO2; COX2; CO2; Cytochrome c oxidase II; MTCO2; COII; COXII应用: WB,IP,IHC,IF反应种属: Human
-
分类: 科研抗体货号: P21688别名: MASK; MST4应用: WB,IP,IF反应种属: Human,Rat
-
分类: 科研抗体货号: P21707别名: Myeloperoxidase; MPO应用: WB,IHC反应种属: Human,Mouse
-
分类: 科研抗体货号: P21687别名: DFNB74应用: WB反应种属: Mouse,Rat
-
分类: 科研抗体货号: P21722别名: My013; C6orf66; HRPAP20; HSPC125; bA22L21.1应用: WB,IP,IF反应种属: Human
-
分类: 科研抗体货号: P21706别名: P0; CHM; DSS; MPP; CMT1; CMT1B; CMT2I; CMT2J; CMT4E; CMTDI3; CMTDID; HMSNIB应用: WB反应种属: Rat
-
分类: 科研抗体货号: P21686别名: DNA mismatch repair protein Msh2; MutS protein homolog 2应用: WB,IP反应种属: Human
-
分类: 科研抗体货号: P21721别名: CGI65; CIA30; Ndufaf1应用: WB,IP,IF反应种属: Human
-
分类: 科研抗体货号: P21705别名: BTN6; BTNL11; MOGIG2; NRCLP7应用: WB,IP反应种属: Rat
-
分类: 科研抗体货号: P21685别名: Testis development protein NYD-SP21应用: WB反应种属: Human,Rat

鄂公网安备42018502007531号
鄂公网安备42018502007531号

